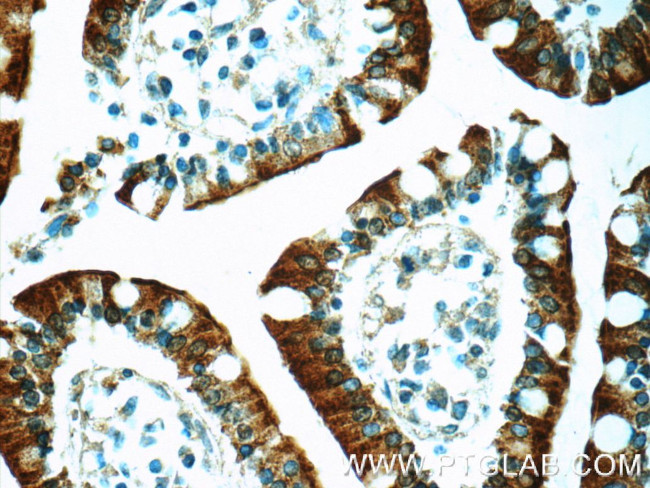
MUPCDH Antibody in Immunohistochemistry (Paraffin) (IHC (P))

Search
Proteintech
MUPCDH Polyclonal Antibody
{{$productOrderCtrl.translations['antibody.pdp.commerceCard.promotion.promotions']}}
{{$productOrderCtrl.translations['antibody.pdp.commerceCard.promotion.viewpromo']}}
{{$productOrderCtrl.translations['antibody.pdp.commerceCard.promotion.promocode']}}: {{promo.promoCode}} {{promo.promoTitle}} {{promo.promoDescription}}. {{$productOrderCtrl.translations['antibody.pdp.commerceCard.promotion.learnmore']}}
产品信息
25619-1-AP
种属反应
宿主/亚型
分类
类型
抗原
偶联物
形式
浓度
规格
纯化类型
保存液
内含物
保存条件
运输条件
产品详细信息
Immunogen sequence: NGTFIIHPD SGNLTVARSV PSPMTFLLLV KGQQADLARY SVTQVTVEAV AAAGSPPRFP QRLYRGTVAR GAGAGVVVKD AAAPSQPLRI QAQDPEFSDL NSAITYRITN HSHFRMEGEV VLTTTTLAQA GAFYAEVEAH NTVTSGTATT VIEIQVSEQE PPSTGGGPSE DKRFSVVDMA ALGGVLGALL LLALLGLAVL VHKHYGPRLK CCSGKAPEPQ PQGFDNQAFL PDHKANWAPV PSPTHDPKPA EAPMPAEPAP PGPASPGGAP EPPAAARAGG SPTAVRSILT KERRPEGGYK AVWFGEDIGT EADVVVLNAP TLDVDGASDS GSGDEGEGAG RGGGPYDAPG GDDSYI (297-651 aa encoded by BC038405)
靶标信息
This gene is a novel mucin-like gene that is a member of the cadherin superfamily. While encoding nonpolymorphic tandem repeats rich in proline, serine and threonine similar to mucin proteins, the gene also contains sequence encoding calcium-binding motifs found in all cadherins. The role of the hybrid extracellular region and the specific function of this protein have not yet been determined. Alternatively spliced transcript variants encoding different isoforms have been described.
仅用于科研。不用于诊断过程。未经明确授权不得转售。
篇参考文献 (0)
生物信息学
蛋白别名: Cadherin; Cadherin-related family member 5; clathrin coated pits integral type 1 membrane protein; DACAR; differentiation-associated catenin regulator; MLPCDH; Mu-protocadherin; Mucin and cadherin-like protein; Mucin-like protocadherin; unnamed protein product
基因别名: CDHR5; MLPCDH; MU-PCDH; MUCDHL; MUPCDH; UNQ2781/PRO7168
UniProt ID: (Human) Q9HBB8
Entrez Gene ID: (Human) 53841